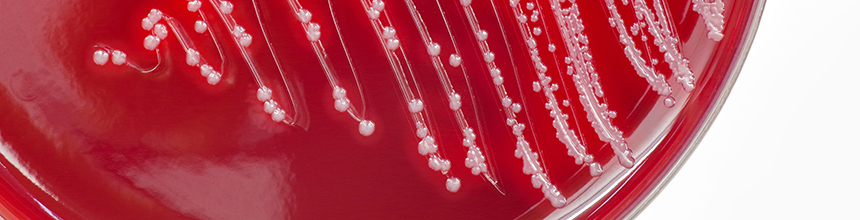

EL
eLearning
Antibacterial agents
Aim
To familiarise healthcare professionals with the antibacterial agents commonly encountered in clinical practice.Learning outcomes
Having completed this course you should be able to:- describe the differences between human (eukaryotic) cells and bacterial (prokaryotic) cells that can be exploited by antibacterial agents
- list the main bacterial cell sites on which antibacterial agents exert their bactericidal or bacteriostatic effects
- define minimum inhibitory concentration and minimum bacterial concentration – the measures of antibacterial susceptibility
- summarise the main issues for each class of commonly encountered antibacterial agent.
Common infections
Aim
To enable healthcare professionals to diagnose and manage common infections.Learning outcomes
Following completion of this course you should be able to:- detail the diagnosis and management of urinary tract infections in different patient groups
- explain the antibiotic prescribing strategy for respiratory tract infections
- detail the management of acute bronchitis in different patient groups
- describe the management of community-acquired pneumonia and hospital-acquired pneumonia
- discuss the treatment of chronic obstructive pulmonary disease exacerbations, sore throats, sinusitis and bronchiecstasis
- recognise common skin and soft tissue infections and know the first- and second-line antibiotics to treat these
- list the risk factors and symptoms associated with sepsis and appreciate the severity of the condition
- detail the recommendations for preventing infections in asplenic patients
Drug selection
Aim
To know the range of factors that must be considered when selecting an antimicrobial agentLearning outcomes
Having completed this course you should be able to:- list the indicators of an infection
- consider whether a patient with an infection requires treatment with an antimicrobial agent
- recognise when empirical or targeted antimicrobial therapy should be chosen
- describe the impact that the site of infection has on choosing antimicrobials
- discuss the patient factors that should be considered when choosing an appropriate antimicrobial agent
- explain the issues associated with topical, parenteral and oral administration of antimicrobials
Other agents
Aim
To familiarise healthcare professionals with the actions and use of commonly encountered antifungal, antiviral and antiprotozoal agents.Learning outcomes
Following completion of this course you should be able to:- describe the actions of antifungal, antiviral and antiprotozoal agents
- differentiate between the main classes of antifungal agents, indicating how each should be used appropriately
- list the commonly used antiviral agents, their dosage form and indications for use
- detail common antiprotozoal drugs and the protozoa they are active against.
Resistance
Aim
To enable healthcare professionals to understand the impact of antimicrobial resistance and to assist with halting the spread of resistance and Clostriodes difficile.Learning outcomes
Having completed this workshop you should be able to:- define antimicrobial resistance
- discuss Clostriodes difficile (C. diff) and the associated problems
- explain Meticillin-resistant Staphylococcus aureus (MRSA) risk factors, diagnosis and treatment
- describe what MRSA screening and decolonisation entails
- detail the problems with extended-spectrum beta-lactamases (ESBLs) and resistant enterococci
- list strategies to halt the spread of C. diff and antimicrobial resistance.
Sepsis Awareness
Aim
To provide an overview of sepsis, thus enabling pharmacists to identify patients presenting with symptoms in the community and to refer them appropriately.Learning outcomes
Having viewed this recorded lecture, you will be able to:- Define sepsis and understand its pathophysiology
- Identify individuals who are at higher risk of developing sepsis from an infection
- Describe the symptoms indicative of sepsis in both adults and children
- Acknowledge the importance of early recognition and know what is appropriate escalation of care
- Understand how the condition is managed in practice
- Appreciate the long-term complications associated with sepsis
- Support patients suffering from post-sepsis syndrome
Stewardship
Aim
To equip healthcare professionals with knowledge of antimicrobial stewardship and infection prevention and control practices in combatting antimicrobial resistance (AMR) across primary and secondary care settings.Learning outcomes
Having completed this course, you should be able to:- define antimicrobial stewardship
- discuss the UK’s latest five-year national action plan (Confronting antimicrobial resistance 2024-2029)
- understand the significance of antimicrobial surveillance
- explain the key components of an effective antimicrobial stewardship programme
- describe a range of antimicrobial stewardship strategies used in primary and secondary care
- define WHO’s AWaRe classification system of antibiotics and its relevance to antimicrobial stewardship
- identify key themes of the UK’s 2023 Antimicrobial Prescribing and Stewardship Competency Framework
- recognise the significance of infection prevention and control interventions
anticoagulation
Aim
To equip learners with the knowledge to deliver a safe and supportive service to patients prescribed anticoagulants.Learning outcomes
On completion of this course you should be able to:- state the indications for anticoagulant therapies
- describe the mode of action of the oral and parenteral anticoagulants that are currently available
- advise on the respective monitoring requirements for vitamin-k antagonists and the newer DOACs
- ensure accurate information is provided to patients and their carers, when reviewing, counselling, initiating or monitoring the use of anticoagulants
- follow best practice guidance to improve the safe use of anticoagulants
- promote safe use of anticoagulants in pregnant women.
atrial fibrillation
Aim
To enable you to provide evidence-based information to patients in primary care who have a diagnosis of atrial fibrillation (AF).Learning outcomes
Having completed this course you should be able to:- define AF, discuss its prevalence and describe the symptoms and complications of AF
- outline the management objectives of AF
- discuss drugs used in rate and rhythm control strategies
- detail the treatment of permanent, persistent and paroxysmal AF
- outline the choice of antithrombotic therapy in AF, including special considerations when prescribing.
Effective mentoring
Aim
To provide individuals with the tools to mentor effectively.Learning outcomes
On completion of this course you should be able to:- explain what mentoring is
- understand the benefits of mentoring
- define the different roles that mentors may perform within the workplace
- identify the skills required to become an effective mentor
- recognise the stages in the mentoring relationship
- conduct effective mentoring meetings in order to get the most out of the mentoring relationship
- effectively mentor an individual in your workplace.
Effective Workplace Training
Aim
To equip individuals with the knowledge required to provide effective workplace training.Learning outcomes
On completion of this course you should be able to:- explain the key features of training
- discuss experiential learning and the learning cycle
- describe the 4 main learning styles
- consider the influence of preferred learning modes and personality types on how individuals learn
- identify the knowledge and skills that are needed by the trainee(s)
- conduct effective training to meet the needs of the trainee(s) and provide the trainee(s) with constructive feedback
- assess the performance of trainees using an evidence-based approach
- identify and resolve problems with training materials, methods and facilities.
The role of a DPP
Aim
To provide a Designated Prescribing Practitioner (DPP) with an overview of the Pharmacist Independent Prescribing programme and their role in mentoring a pharmacist.Learning outcomes
Having completed this course you should be able to:- outline the role of a pharmacist independent prescriber
- describe the structure and purpose of the period of learning in practice
- list the learning outcomes of the Pharmacist Independent Prescribing course
- outline your role as a DPP
- explain what mentoring is
- understand the benefits of mentoring
- identify the skills required to become an effective mentor
- recognise the stages in the mentoring relationship
The Role of the Designated Prescribing Practitioner during FTY
Aim
To provide a Designated Prescribing Practitioner (DPP) with an overview of the Foundation Training Year (FTY) programme and their role in supervising and assessing a trainee pharmacist during the Prescribing Practice Period (PPP).Learning outcomes
On completion of this course you should be able to:- outline the background to FTY 2025/26
- differentiate between the roles of an Educational Supervisor (ES), Practice Supervisor (PS) and DPP
- describe the structure and purpose of the 90 hours PPP
- explain the nominated prescribing area, prescribing practice activities (PPAs) and PPP log
- know how to raise concerns
- understand your role in assessment and PPP completion report.
Classification and diagnosis
Aim
To provide a general overview of the condition, diabetes mellitus.Learning outcomes
Having completed this course, you should be able to:- classify diabetes mellitus into its four distinct types according to aetiology
- provide estimates for the increasing prevalence of the disease by geographical location
- list the signs and symptoms of diabetes and the criteria for its diagnosis
- state the acute and long-term complications of diabetes
- describe the key objectives for the organisation of diabetic services.
Diabetes in pregnancy
Aim
To understand the impact of diabetes in pregnancy and appropriate management strategies.Learning outcomes
Having completed this course, you should be able to:- list the main risks to mother and baby of diabetes in pregnancy
- describe the key health promotion issues to minimise the risk factors during pregnancy
- propose changes to treatment, where appropriate, for women with diabetes who are pregnant to ensure optimal control
- provide guidance on the management of gestational diabetes.
Diabetic emergencies
Aim
To be able to recognise and appropriately manage a diabetic emergency.Learning outcomes
Having completed this course, you should be able to:- list the acute complications of diabetes
- describe the symptoms associated with hypoglycaemia, hyperglycaemia, diabetic ketoacidosis and the hyperosmolar hyperglycaemic state
- make recommendations for how each type of emergency should be managed
- provide advice to patients on the course of action they should adopt when they are unwell.
Glycaemic and metabolic monitoring
Aim
To be able to effectively monitor control of the condition for those with diabetes.Learning outcomes
Having completed this course, you should be able to:- provide advice to patients on testing of blood glucose
- make recommendations for glycaemic control based on the results of glycated haemoglobin testing
- recognise the pivotal role of patient education in empowering people with diabetes to better manage their condition
- list management targets for metabolic control to include the surveillance approaches for the early detection of diabetes complications (blood glucose, blood pressure and blood lipids).
Long term complications
Aim
To prevent the development of long-term complications of diabetes or manage them should they occur.Learning outcomes
Having completed this course, you should be able to:- describe the microvascular and macrovascular complications of diabetes
- list the risk factors for developing microvascular and macrovascular complications
- describe how the management of risk factors can reduce the likelihood of diabetic patients developing these complications
- outline current guidelines for the treatment of hypertension and dyslipidaemia in patients with diabetes.
Managing Type 1 diabetes
Aim
To be able to effectively assist patients with type 1 diabetes in managing their blood glucose.Learning outcomes
Having completed this course, you should be able to:- outline the metabolic effects of insulin
- describe the differences between the main types of insulin
- discuss the various treatment regimens
- provide practical advice to patients on injection devices
- critically evaluate the evidence-base for tight glycaemic control as a means to preventing complications
- promote the safer use of insulin.
Managing Type 2 diabetes
Aim
To be able to effectively assist patients with type 2 diabetes in managing their blood glucose.Learning outcomes
Having completed this course, you should be able to:- Update on the drugs used to manage Type 2 diabetes, including SGLT2 inhibitors and GLP-1 agonists
- Inclusion of the new NICE algorithms for initiating anti-diabetic medications ( for patients with and without CV disease)
- The earlier use of SGLT2 inhibitors in treatment, due to renal and cardiovascular protection
- Additions to the SADMAN criteria for SICK DAY rules and evidence from early Diabetes Remission trials and clinics
Risk factors and prevention
Aim
To understand the risk factors for diabetes and the likelihood of developing the condition.Learning outcomes
Having completed this course, you should be able to:- identify the main modifiable and non-modifiable risk factors for developing diabetes
- state the evidence base that supports healthy lifestyle interventions as a means of preventing type 2 diabetes
- outline healthy lifestyle choices for people with diabetes and those at risk of developing diabetes.
Part 1 - Introduction to equality, diversity and inclusion
Aim
To increase awareness of EDI principles, as well as anti-discrimination and human rights legislation relevant to Northern Ireland, to help pharmacists, pharmacy trainees and pharmacy technicians consider how to provide culturally inclusive and patient-centred care.Learning outcomes
Having completed this course, you should be able to:- define equality, diversity, and inclusion (EDI) and its significance
- outline the anti-discrimination legislation specific to Northern Ireland
- discuss the roles and responsibilities of organisations and healthcare professionals in Northern Ireland in promoting equality of opportunity and good relations
- identify what constitutes discrimination, understand implicit vs explicit bias and recognise the importance of avoiding stereotypes
- appreciate the significance of human rights legislation in healthcare delivery
- understand disability equality in Northern Ireland, including relevant legislation and the duty to make reasonable adjustments.
Part 2 - Cultural competence and avoiding microaggressions
Aim
To increase awareness about effectively engaging and communicating with individuals from diverse cultural and ethnic backgrounds.Learning outcomes
Having completed this course, you should be able to:- describe the term cultural competence and its significance the provision of healthcare, working with colleagues and supervising trainees
- understand what a microaggression is and how to effectively respond to and challenge when you witness a microaggression
- outline the steps to effectively support someone who has experienced a microaggression
- appreciate the importance of using inclusive language when communicating with others
- describe how to respond if you have inadvertently made a mistake with language.
Part 3 - Neurodivergence awareness
Aim
To raise awareness and improve understanding of neurodivergence among pharmacists, technicians, trainees and educational supervisors and to enable them to create inclusive and supportive environments, reduce stigma and promote acceptance of neurodivergence within pharmacy healthcare, workplaces and training settings.Learning outcomes
Having completed this course, you should be able to:- understand the term neurodivergence and neurodiversity and recognise key characteristics of dyslexia, ADHD, dyscalculia, dyspraxia and autism
- discuss the impact of neurodivergent conditions in the workplace and training environments
- describe a range of common adjustments to accommodate neurodivergent employees and trainees
- use inclusive and respectful language and avoid neurodivergent microaggressions
- explain common strategies for creating an inclusive workplace and training cultures that value neurodivergence
- discuss common approaches to reduce stigma around neurodivergent conditions, such as autism.
Part 4 - LGBTQIA+ and gender identity awareness
Aim
To enhance awareness and understanding of gender identity and LGBTQIA+ issues among pharmacists, supervisors, trainees, and technicians, empowering them to foster inclusive and supportive environments, reduce stigma and encourage acceptance within workplace and training settings.Learning outcomes
Having completed this course, you should be able to:- recognise the impact of discrimination on LGBTQIA+ and gender-diverse people
- understand the terminology associated with LGBTQIA+ and gender identity
- identify practices that help create LGBTQIA+ friendly environments and acceptance of different gender identities in healthcare, workplace and training environments
- apply inclusive language to create a welcoming workplace and training environment.
Controlled drugs - striking a balance
Aim
To review the implications of the Fourth Report of the Shipman Inquiry, focusing specifically on the prescribing, dispensing, safe custody and disposal of controlled drugs.Learning outcomes
On completion of this course you should be able to:- comply with legislation underpinning controlled drugs
- state changes in the legislative framework for controlled drugs arising from the Fourth Shipman Report
- review the role and responsibilities of the Accountable Officer in relation to controlled drugs
- list the non-medical professions who may now prescribe
- describe best practice with respect to writing of prescriptions, keeping of records and maintaining prescription security for controlled drugs in all areas of practice
- define procedures for the disposal of returned controlled drugs.
Part 1 - Understanding pain
Aim
To provide healthcare professionals with an understanding of modern approaches for effective, patient-centred pain management and promote awareness of the lived experience of people who have to live with pain daily.Learning outcomes
Having completed this course, you should be able to:- define the phenomenon of pain
- understand the prevalence, epidemiology and impact of pain
- explain the "Biopsychosocial model of pain" and its importance in delivering patient-centred care
- understand the impact of pain from a patient's perspective and how it affects their quality of life
- describe the mechanisms and pathophysiology of pain
- understand the different pain classification systems and their significance.
Part 2 - Pain management and assessment
Aim
To help healthcare professionals understand modern patient-centred approaches to pain management frameworks, pain assessment tools and strategies for enhancing self-management skills.Learning outcomes
Having completed this course, you should be able to:- outline the NICE stepped approach for treating mild to moderate acute pain
- understand the latest NICE guidance for treating chronic pain, encompassing primary and secondary chronic pain
- explain NICE-recommended non-pharmacological approaches for chronic pain management
- summarise the treatment and management of non-malignant neuropathic pain
- discuss various approaches and tools for pain assessment
- describe approaches to foster effective self-management of pain by patients, shared decision-making and communicating risks associated with dependence-forming medicines
Part 3 - Analgesics
Aim
To provide healthcare professionals with a better understanding of the pharmacological properties of the main analgesic drug groups and other pain treatments used in clinical practice.Learning outcomes
Having completed this course, you should be able to:- describe the pharmacological properties of the main types of analgesics used in the management of different types of pain
- understand how to manage the risks and potential harms associated with opioids
- recognise the signs of opioid tolerance, dependence, toxicity, withdrawal and other harms
- explain the main safety considerations for different types of analgesics
- discuss the use of adjuvant analgesics in pain management
Part 4 - Specific Groups
Aim
To provide healthcare professionals with a better understanding of pain management and treatment in specific patient groups such as older people, pregnant women and cancer patients.Learning outcomes
Following completion of this course you should be able to:- list the physiological factors that need considered with infants and older people when recommending analgesia
- discuss the management of non-labour pain during pregnancy and treatment of labour pain
- describe the analgesic options during breastfeeding
- understand approaches to postoperative pain
- define palliative care
- describe the World Health Organisation's Cancer Pain Ladder and strategies for managing cancer pain
- understand the priorities when providing end of life care.
End of Life Care
Aim
To consider the role pharmacists have in supporting individuals in the last days of lifeLearning outcomes
Having completed this course you should be able to:- Recognise the signs that suggest a person is entering the last days of life.
- Locate the resources available to support good end of life care.
- Suggest medicines to support the management of symptoms that can affect patients in the last days of life.
- Understand the principles of anticipatory prescribing.
- Support the safe use of subcutaneous medicines to provide symptom control.
- Provide support and reassurance to family and carers, signposting to other services accordingly.
high-risk medicines - Insulin
Aim
To promote the safer use of insulin in clinical practice.Learning outcomes
At the end of this course you should be able to:- identify the errors commonly encountered with insulin
- describe the possible clinical consequences associated with insulin
- list the causes of medication incidents involving insulin
- implement strategies to reduce the risks with insulin
- safeguard patients by providing them with appropriate information about their insulin
- promote staff education and safe systems of practice as effective means of reducing medication errors associated with insulin
high-risk medicines - Opioids
Aim
To promote the safer use of opioids in clinical practice.Learning outcomes
At the end of this course you should be able to:- list the causes of medication incidents involving opioids
- describe the possible clinical consequences associated with opioids
- implement strategies to reduce the risks with opioids
- safeguard patients by providing them with appropriate information about their opioids
- promote staff education and safe systems of practice as effective means of reducing medication errors associated with opioids
high-risk medicines - Oral anticoagulants
Aim
To promote the safer use of oral anticoagulants in clinical practice.Learning outcomes
Following completion of this course you should be able to:- list the causes of medication incidents involving oral anticoagulants
- describe the possible clinical consequences associated with oral anticoagulants
- implement strategies to reduce the risks with oral anticoagulants
- safeguard patients by providing them with appropriate information about oral anticoagulants
- promote staff education and safe systems of practice as effective means of reducing medication errors associated with oral anticoagulants
breastfeeding
Aim
To enable you to provide evidence-based advice to breastfeeding mothers and those who are wanting to breastfeedLearning outcomes
Following completion of this course you should be able to:- understand the benefits of breastfeeding
- identify common issues encountered in practice relating to breastfeeding
- provide accurate and safe information to breastfeeding mothers on the use of medicines in breastfeeding
- promote the role of pharmacists in supporting breastfeeding mothers
- signpost to relevant sources of help for breastfeeding mothers in Northern Ireland.
brief interventions
Aim
To equip healthcare professionals (HCPs) with the knowledge and skills necessary to deliver an effective brief interventions in practice.Learning outcomes
Following completion of this course you should be able to:- define what is meant by a brief intervention
- apply the model of behaviour change to your practice
- outline the principles of effective communication
- raise the subjects of smoking, alcohol consumption or physical inactivity with patients in routine practice and record intervention in patient notes
- assess patient/clients for risk and their motivation to change
- advise on the risks to health posed by smoking, alcohol and physical inactivity
- assist patients/clients by signposting and providing additional information sources.
inhaler devices
Aim
To enable healthcare professionals to provide effective care for patients requiring inhalation therapy for the management of asthma and COPD.Learning outcomes
Having completed this course, you should be able to:- outline the range of inhaler devices currently available for use in treating asthma and COPD
- list and describe the advantages and disadvantages of the different types of inhaler devices
- demonstrate the correct use of each of these devices
- advise on the use of spacer devices where appropriate
- provide advice regarding the most appropriate inhaler device for a particular patient group.
menopause management
Aim
To enable you to provide evidence-based medical advice to women experiencing the menopause.Learning outcomes
Having completed this course you should be able to:- recognise the symptoms experienced by women around the time of the menopause
- identify patients who may benefit from hormone replacement therapy (HRT)
- recognise the different types of HRT available and their appropriateness for individual patients
- provide advice to patients on the risks and contra-indications to HRT
- raise awareness of alternatives to HRT therapy and self-help techniques for managing menopausal symptoms.

.jpg)






